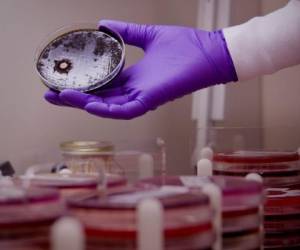

En marzo de 2020, cuando el letal virus ingresó al país, David estaba en sexto grado y Génesis en tercero, ambos en la Escuela Club de Leones de El Picacho. Desde entonces no volvieron a las aulas y sus mentores desaparecieron. Por falta de recursos económicos, su madre Yeni Elizabeth Medina no pudo comprarles un teléfono móvil ni internet para que al menos semanalmente recibieran alguna instrucción de sus maestros. ¿Y papá? Murió... respondió Carlos David, inclinando su rostro para ocultar su tristeza.
DE INTERÉS: Nadie lo sabía: Sorpresa por ZEDE en San Marcos de Colón
El poco interés de los docentes en por lo menos conocer las condiciones de estos escolares y auxiliarlos en lo posible también sentencia a estos niños a una dolorosa realidad. Ni las tabletas desfasadas de la Secretaría de Educación alcanzó para ellos.
Este solo es un caso que refleja las múltiples injusticias sociales existentes en el país, donde el Estado no tiene recursos económicos para atender a estos pequeños —que como ellos hay muchos en iguales condiciones—, pero sí posee dinero para pagar 58 millones de lempiras en viáticos a 128 diputados, que durante todo el 2020 permanecieron en casa, legislando virtualmente de vez en cuando, pero causando mucho daño a la sociedad.
Cifras alarmantes
Si antes de la pandemia las cifras sobre la situación de los niños en Honduras era preocupante, ahora, tras 15 meses de crisis sanitaria, el escenario es desconcertante y sobre todo indignante por la indiferencia gubernamental.VEA: Congreso Nacional dio 57 millones en viáticos a diputados; pese a sesionar virtualmente
Un análisis de la organización Visión Mundial, basada en los datos del Instituto Nacional de Estadística (INE) y de la realidad, precisa que Honduras posee una población de 9.1 millones de habitantes, de los cuales 5.6 millones son adultos y 3.5 millones son niños.
De esta cantidad de menores, 1,812,548 solo estudian; por otro lado 364,765 niños, niñas y adolescentes —entre cinco y 17 años de edad— trabajan; igualmente está la cifra de 284,813 que ni trabajan ni estudian.
Estos datos, según nota de prensa de Visión Mundial, muestran que a nivel nacional el 73.6% de la niñez y adolescencia se dedica sólo a estudiar, el 14.8% trabaja (incluye los que estudian y trabajan y los que solo trabajan) y un 11.6% que ni estudia ni trabaja (donde las niñas son mayoría, 64.7%, contra el 35.3% de niños), comportamiento similar se observa en el área urbana y rural.
De los 364,765 menores que trabajan con edades entre cinco y 17 años de edad, el 66.8% se concentra en el área rural, mientras que el restante 33.2% está en el área urbana. Del total de la población que trabaja, el 73.7% son niños y el 26.3% son niñas.
El trabajo infantil se agrupa principalmente en las actividades de Agricultura, Silvicultura, Caza y Pesca (48.3%), Comercio por Mayor / menor (18.5%), Industria manufacturera (7.6%) y Construcción (3.8%).
ES DE INTERÉS: Congreso Nacional erogó 644.4 millones de lempiras en pago de salarios y beneficio
Por otro lado, los datos muestran que el Estado a pesar de tener un compromiso internacional, bajo la iniciativa global Alianza 8.7 por un mundo libre de trabajo forzoso, esclavitud moderna, trata de personas y trabajo infantil, en esta última área no ha hecho mucho.
En 2013 Honduras registraba un total de 351,522 niños laborando en diferentes sectores; para el 2019 la cifra había ascendido a 364,765 menores en trabajo infantil.
Además de los niños en las actividades de la agricultura, minería, servicios domésticos y trabajo en la calle, también están aquellas víctimas de las peores formas de trabajo como la explotación sexual comercial, actividades ilícitas y esclavitud.
Para mantener ocupados a esos niños que por falta de recursos no pueden asistir a clases, Omar Serpaz, un voluntario de la comunidad de La Estanzuela, donde vive Carlos David y Génesis Zulema, se dedica a formar equipos de fútbol con los menores.
“Esta es una manera de mantenerlos ocupados y así evitar que piensen hacer cosas incorrectas”, explicó el voluntario.
Generación perdida
Las estadísticas muestran que el país está al borde de perder a toda una generación, por la falta de diligencia estatal en la atención de más de medio millón de niños, que se han visto obligados a cambiar su entretenimiento infantil por un trabajo.VEA: Cuarterías repletas de migrantes en Choluteca: asustados, evasivos y desesperados
Según Jorge Valladares, director del proyecto Futuros Brillantes de Visión Mundial, “la pandemia ha incrementado de una forma terrible el trabajo infantil. Como no están en la escuela entonces se dedican a las actividades de fortalecimiento de la economía familiar”.
Recordó que antes de la llegada del coronavirus, Honduras tenía cifras que la ubicaban a nivel latinoamericano entre los países con peores indicadores en este tema. Presentaba alrededor de 411 mil niños trabajando, pero al sumar el trabajo oculto las cifras superaban los 500,000.
DE INTERÉS: El gobierno de Honduras entrega tabletas desfasadas y bloqueadas
“El trabajo oculto es el de servicios domésticos por ejemplo, el que se hace en el sector informal de la economía, también están las peores formas de trabajo infantil que no se ve como el buceo submarino en La Mosquitia, en la región atlántica, los niños que están trabajando en las coheterías, en las minerías, que están en la extracción de los curiles en la zona sur”.
Las cifras proporcionadas por el INE dicen que de los 2.8 millones de niños que tiene el país, “solo el 63 por ciento está asistiendo a un centro educativo, ojo, que están matriculados. Imagínese que 1.8 millones de niños están fuera del sistema educativo. Como bien dice el informe global, existe el riesgo de tener una generación perdida en términos de acceso a educación”, reflexionó el director del proyecto Futuros Brillantes —financiado por el Departamento del Trabajo de Estados Unidos— tras demandar una estrategia para que los niños vuelvan a clases.
LEA: Haitianos viven pesadilla en Honduras: 'Violan a las mujeres, matan cuando no hay plata, me robaron todo'
Mientras no se regrese a clases, Carlos David y Génesis Zulema seguirán ahí en su colonia La Estanzuela, extrañando su salón, a sus compañeros y bajo el riesgo de volverse parte de las estadísticas de los niños trabajadores.